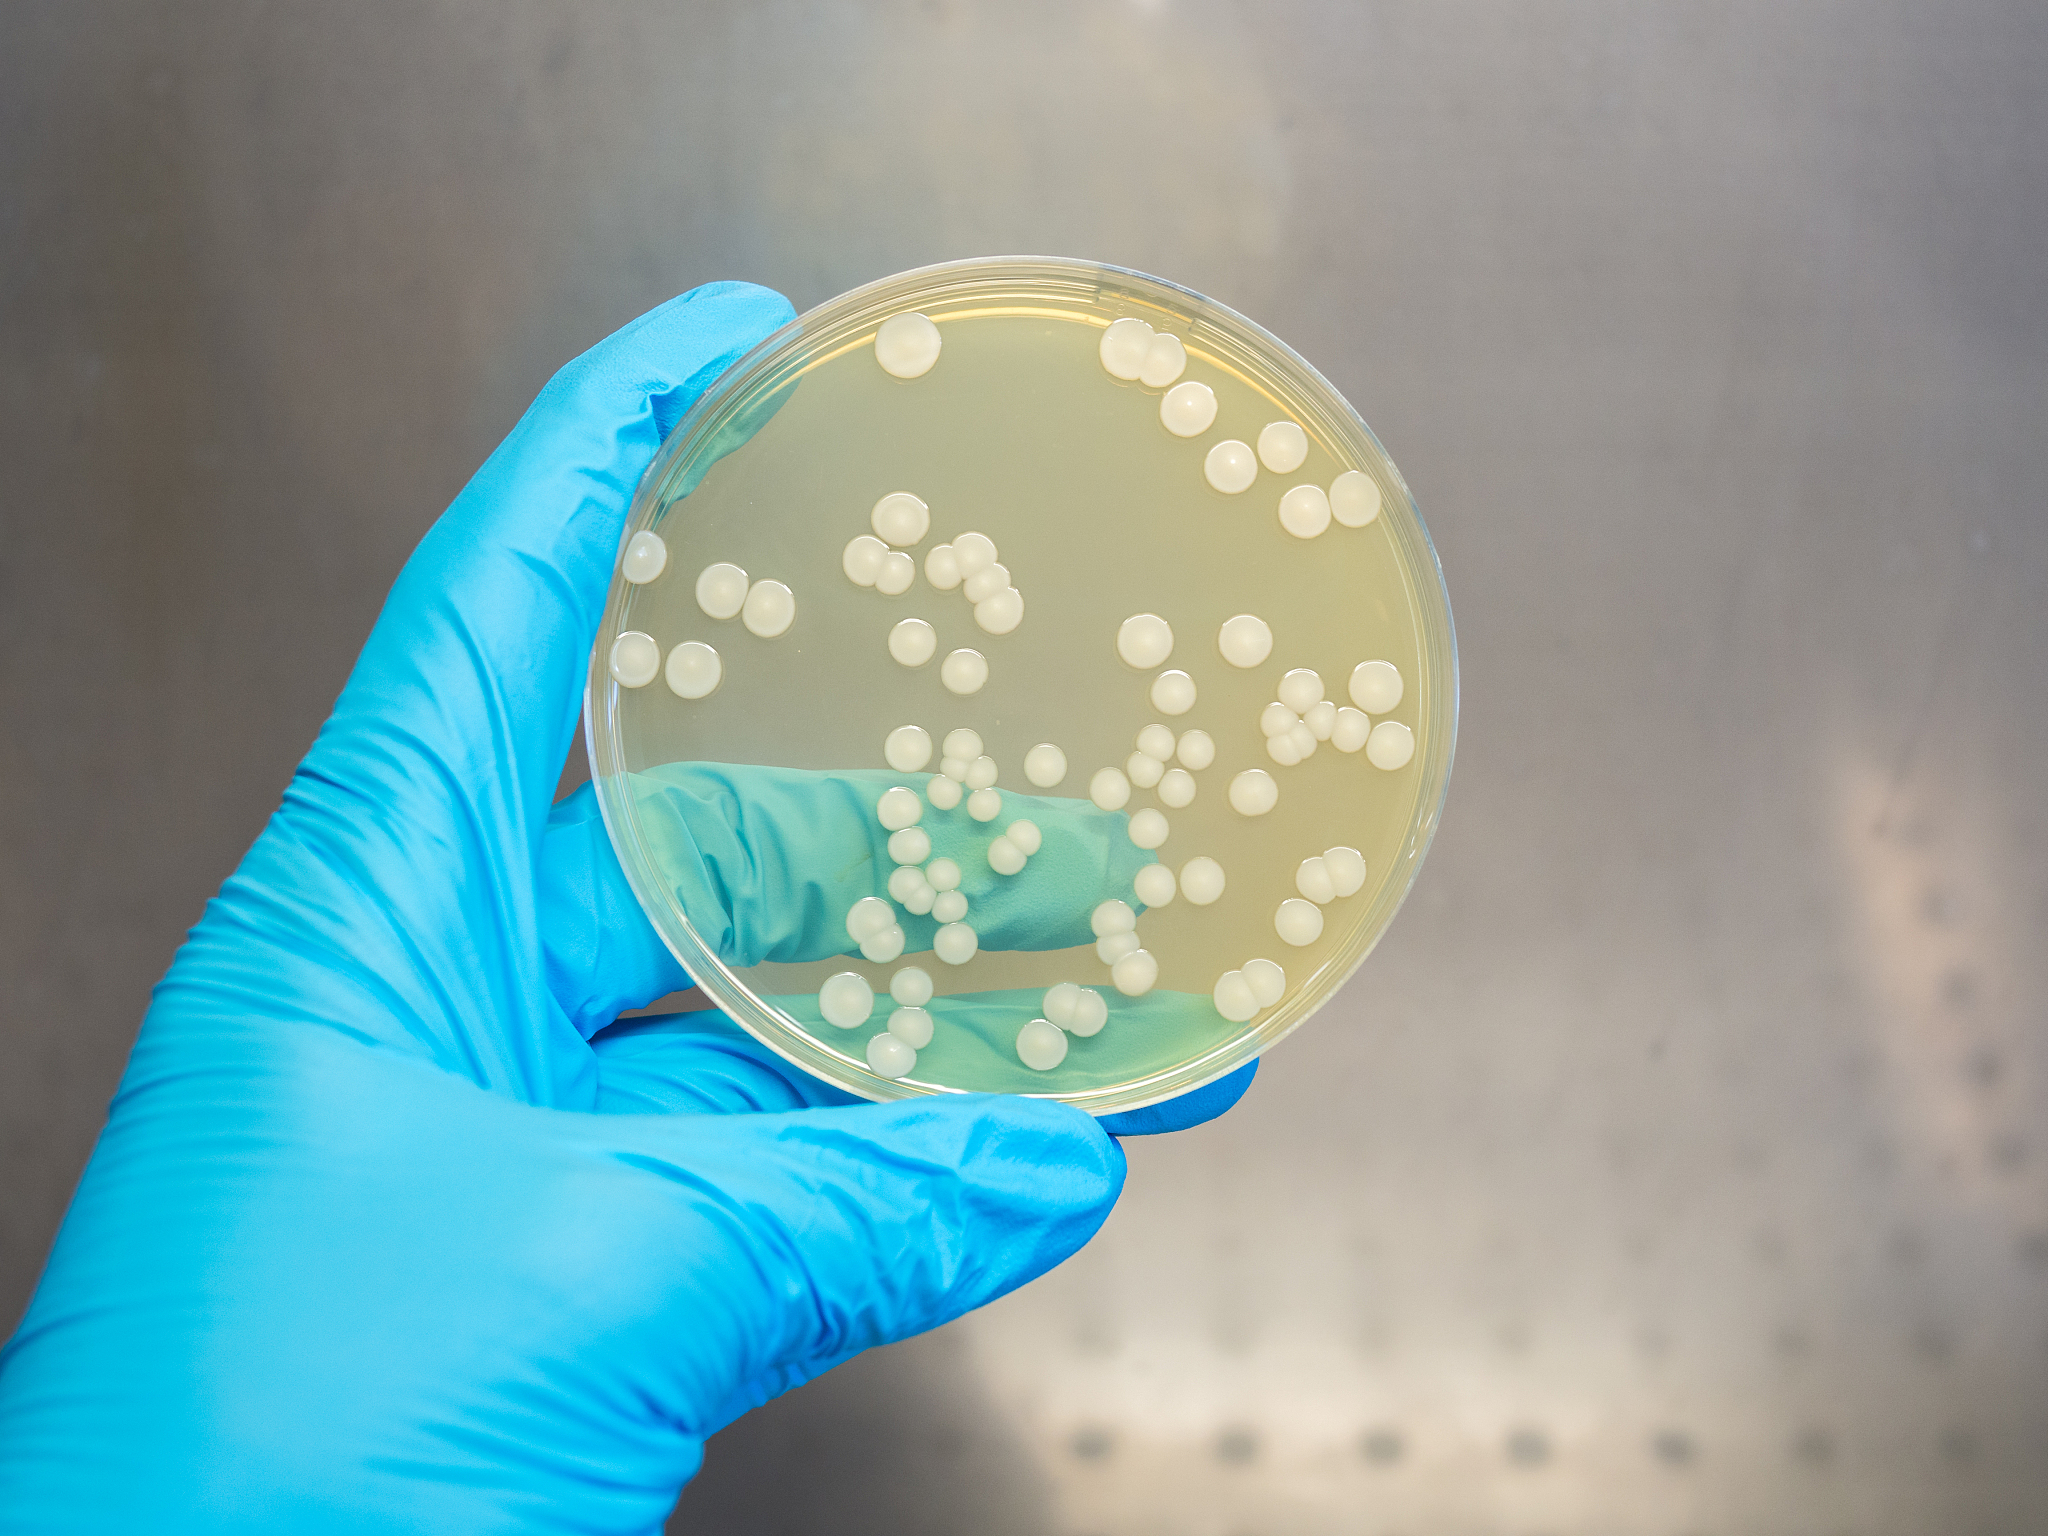
手部和手机触摸屏微生物菌群分析实验报告

手部和手机触摸屏微生物菌群分析实验报告
实验报告
一、实验目的
本实验旨在收集和分析手部和手机触摸屏上微生物菌群的组成和数量,探究两者之间的联系。
二、实验原理
手部和手机触摸屏上的微生物菌群是人们日常生活中常见的微生物群落,可以通过采集样本并在血平板上进行培养和鉴定来分析其组成和数量。
三、实验步骤
-
实验前准备:准备好所需的血平板、无菌棉签、手套、口罩、75%酒精、洗手液等实验器材和保护用品。
-
取样:首先,实验者需穿戴鞋套、白大褂、手套和口罩,避免手部菌群污染样本。然后,用无菌棉签在手机触摸屏经常擦拭数次,收集手机上的微生物样本。其次,用无菌棉签在手掌、手指、指甲等部位擦拭,收集手部微生物样本。
-
培养和培养:将收集到的样本分别在不同的血平板上进行培养18~24小时后观察菌落种类形态。
-
菌落统计和鉴定:在血平板上出现的菌落,进行质谱鉴定,确定不同菌落的种类和数量。
-
根据实验结果,分析手部和手机触摸屏上微生物菌群的组成和数量,探究两者之间的联系。
四、实验结果
经过培养和鉴定,得到以下结果:
A1、A4、A5为表皮葡萄球菌,属于手部微生物菌群;A2为人葡萄球菌,属于手部微生物菌群;A3为金黄色葡萄球菌,属于手部微生物菌群;A2、A4为手机上的微生物菌群。
五、实验分析
从实验结果可以看出,手部和手机触摸屏上的微生物菌群都包括表皮葡萄球菌、人葡萄球菌和金黄色葡萄球菌等种类,但是数量和比例存在差异。手部微生物菌群中表皮葡萄球菌居多,而手机上的微生物菌群则以人葡萄球菌和金黄色葡萄球菌为主。这可能与手部经常接触物品,容易受到表皮葡萄球菌等常见微生物的污染有关;而手机触摸屏有较多的人葡萄球菌和金黄色葡萄球菌,可能是因为手机经常被人使用,受到人体微生物的污染。
六、实验结论
通过本实验我们得出的结论是:手部和手机触摸屏上的微生物菌群都包括表皮葡萄球菌、人葡萄球菌和金黄色葡萄球菌等种类,但是数量和比例存在差异。手部微生物菌群中表皮葡萄球菌居多,而手机上的微生物菌群则以人葡萄球菌和金黄色葡萄球菌为主。这为我们在日常生活中注意手部卫生和定期清洁手机提供了参考。
七、实验注意事项
-
实验者需要穿戴鞋套、白大褂、手套和口罩,保证样本采集和处理的无菌性。
-
采集样本前需要用75%酒精和洗手液进行手部消毒,避免手部菌群污染样本。
-
采集样本时需要用无菌棉签,避免样本受到其他微生物的污染。
-
在培养和鉴定过程中需要注意无菌操作,避免微生物污染。
-
实验结束后需要对实验器材和工作区域进行消毒处理,保证实验室环境的清洁。
原文地址: https://www.cveoy.top/t/topic/oV2V 著作权归作者所有。请勿转载和采集!